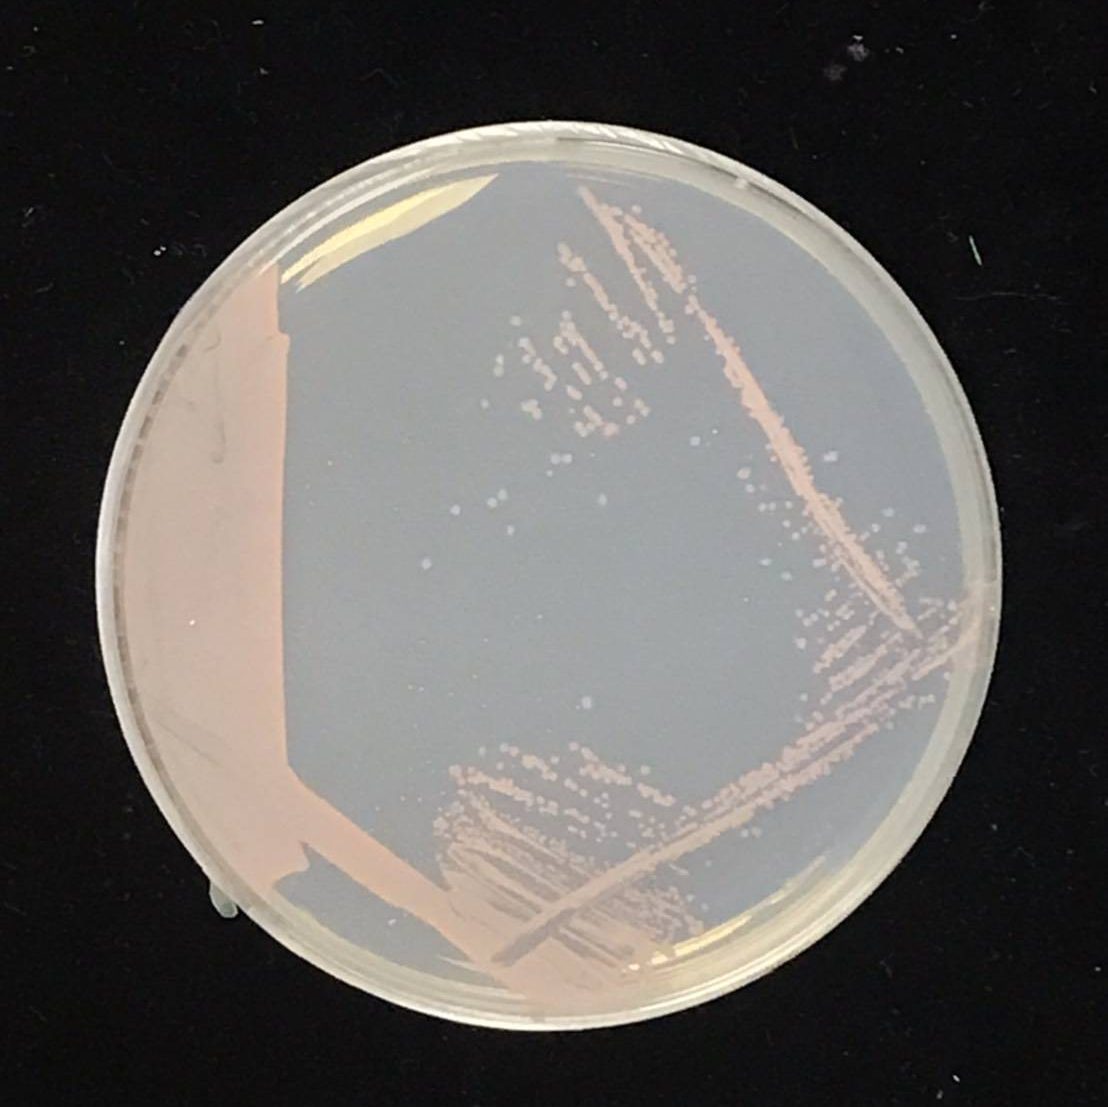

計畫名稱
建立甲基菌於吡咯喹啉醌之量化生產技術
主要營業項目
胜肽合成技術、保養品活性成分原料、保養品半成品內外銷、保健食品開發

計畫緣起
文明社會帶來的高齡化人口及健康意識提升,因此保健食品需求量大幅提升,可預期開發具有預防高齡化疾病之保健食品將會是極具市場競爭力之產品,吡咯喹啉醌(Pyrroloquinoline quinone, PQQ)為紅褐色的具有強氧化還原活性的芳香三環鄰醌類化合物,存在於許多不同生物體內,主要扮演脫氫酶的氧化還原輔助因子,PQQ具有多種生理功能,包括緩解炎症、增強腦功能、抗氧化、促進粒線體功能、降低膽固醇、改善睡眠及疲勞等功能,可廣泛開發於食品、化妝品及醫藥領域,尤其以維持腦健康的保健食品更是銀髮產業主要注目商機之一,近期研究發現PQQ具有相當大的氧化循環能力,在抗神經細胞衰老和抗癌等方面有很大的應用潛力。再者美國食品和藥物管理局(Food and Drug Administration, FDA)早於2008年批准以PQQ為新膳食成分(New Dietary Ingredient, NDI),目前全球微生物來源的PQQ原料主要由日本Mitsubishi Gas Chemical公司供應,然而隨著PQQ原料市場需求的增加,將會有更多企業投入PQQ原料生產之開發,因此本計畫積極投入開發微生物生產PQQ之量產技術,以加快PQQ原料生產及其保健食品之開發速度,期望能於銀髮產業所帶來的無限商機中搶得一席之地。
計畫重點
本計畫首先建立吡咯喹啉醌(PQQ)潛力菌株的篩選平台,先以可利用甲醇的快速生長菌株為初篩首要條件,再進一步於249nm和325nm波長下快速分析PQQ生產量,最終篩選出1株最佳PQQ潛力生產菌株。將篩選出的PQQ潛力菌株利用搖瓶規模探討PQQ發酵參數的合適實驗範圍,再以回應曲面法探討PQQ最適化發酵製程,找出最大化PQQ潛力菌株生長速率和PQQ產率的最適化參數值,接著探討PQQ潛力菌株的發酵規模放大,先以5-L發酵槽探討通氣量、攪拌速率及pH等發酵條件之外,也利用培養液的半連續置換策略,除了可減少因代謝物所產生的生長抑制作用和補充菌株所需的營養源以促進菌體生長之外,還能再次誘導菌株生產PQQ,達到PQQ產量提升和穩定PQQ生產製程之雙重效益,最後建構PQQ潛力菌株菌株可穩定生長和生產PQQ的250-L發酵量產製程,PQQ產量可達315 mg/L,並將此PQQ粗萃物利用MTT assay進行人類胚胎腎臟細胞HEK 293的體外細胞存活性試驗,結果顯示無細胞安全性之疑慮。
計畫創新
- 國內尚無廠商建立自主生產PQQ原料之技術,公司可望成為國內第一家可自主生產微生物來源之PQQ原料的廠商。
- 美國FDA已將PQQ認可為GRAS成分,但國內尚未將PQQ列於正面表列的可供食品使用原料,藉由微生物生產PQQ技術之建立,促進國內申請PQQ的非傳統性食品安全性評估,加速PQQ盡早投入龐大的保健食品市場,未來更可進一步申請具特定功效的健康食品認證。